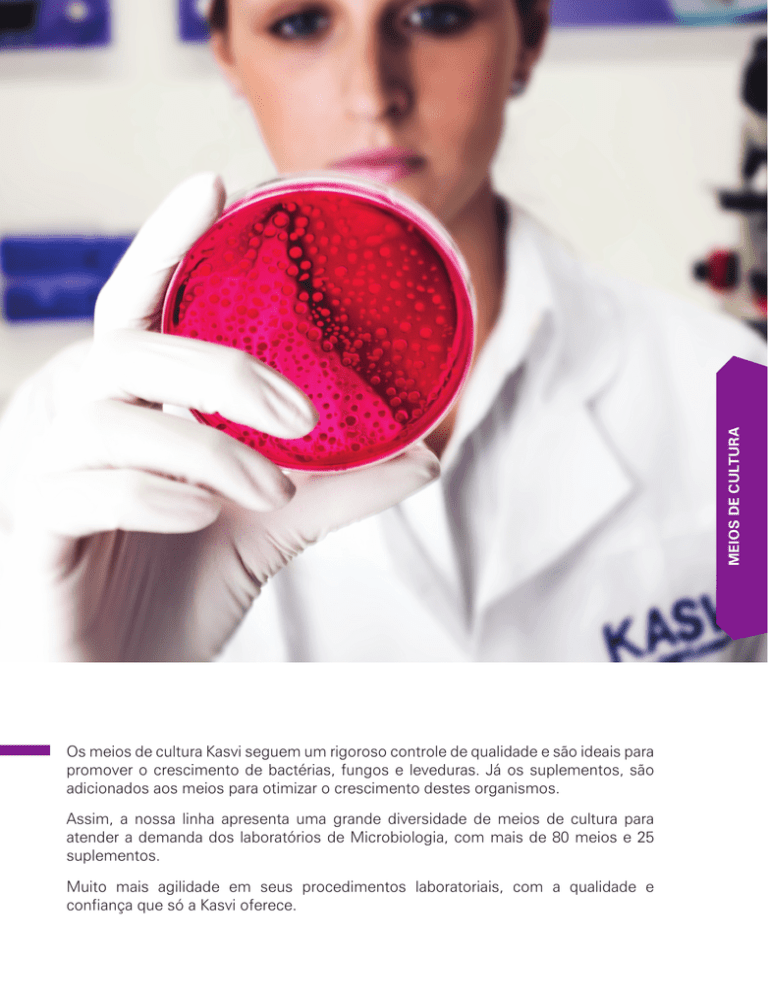

meios de cultura
Os meios de cultura Kasvi seguem um rigoroso controle de qualidade e são ideais para
promover o crescimento de bactérias, fungos e leveduras. Já os suplementos, são
adicionados aos meios para otimizar o crescimento destes organismos.
Assim, a nossa linha apresenta uma grande diversidade de meios de cultura para
atender a demanda dos laboratórios de Microbiologia, com mais de 80 meios e 25
suplementos. Muito mais agilidade em seus procedimentos laboratoriais, com a qualidade e
confiança que só a Kasvi oferece.
meios de cultura
meios de cultura
modelo
descrição
apresentação
K25-611001
Agar Bacteriológico
Frasco 500 g
K25-610004
Aagar Baird-Parker Base
Frasco 500 g
K25-610153
Agar Base Azida Sangue
Frasco 500 g
K25-610114
Agar Base Bacillus Cereus (Mossel)
Frasco 500 g
K25-610013
Agar Base Columbia
Frasco 500 g
K25-610134
Agar Base M-Enterococcus
Frasco 500 g
K25-611012
Agar Base M-FC
Frasco 500 g
K25-610092
Agar Base XLT 4
Frasco 500 g
K25-610102
Agar Batata Dextrose
Frasco 500 g
K25-610210
Agar Bile Esculina
Frasco 500 g
K25-610059
Agar Bile Vermelho Violeta Glicose
Frasco 500 g
K25-610058
Agar Bile Vermelho Violeta Lactose
Frasco 500 g
K25-610041
Agar Cetrimide
Frasco 500 g
K25-610046
Agar Citrato Simmons
Frasco 500 g
K25-620012
Agar CLED
Frasco 100 g
K25-610012
Agar CLED
Frasco 500 g
K25-610096
Agar Clostridial Reforçado
Frasco 500 g
K25-610207
Agar Clostridium perfringens (SFP/TSC)
Frasco 500 g
K25-610040
Agar Contagem de Placas
Frasco 500 g
meios de cultura
Fabricados através de um rigoroso controle de qualidade, os
meios de cultura Kasvi foram especialmente desenvolvidos
para atender à demanda de todos os laboratórios que analisam
microrganismos em suas rotinas. Adequados para promover o
crescimento de bactérias, fungos e leveduras nas mais diversas
áreas de análise.
Imagens meramente ilustrativas. Produtos não passíveis de regulamentação,
conforme estabelece a nota técnica n° 001/2012/GEVIT/GGTPS/ANVISA.
143
Modelo
meios de cultura
Descrição
Apresentação
K25-610095
Agar Czapek Dox
Frasco 500 g
K25-610198
Agar Dextrose Triptona
Frasco 500 g
K25-610237
Agar Dicloran Rosa Bengala Cloranfenicol Base (DRBC)
Frasco 500 g
K25-610019
Agar Eosina Azul de Metileno (EMB Levine)
Frasco 500 g
K25-610089
Agar Extrato Glicose Triptona
Frasco 500 g
K25-610039
Agar Fenilalanina
Frasco 500 g
K25-610021
Agar Hektoen Entérico
Frasco 500 g
K25-620007
Agar Infusão Cérebro e Coração (BHI)
Frasco 100 g
K25-610007
Agar Infusão Cérebro e Coração (BHI)
Frasco 500 g
K25-610023
Agar Kligler Ferro (KIA)
Frasco 500 g
K25-610027
Agar Lisina Ferro (LIA)
Frasco 500 g
K25-620028
Agar Mac Conkey
Frasco 100 g
K25-610028
Agar Mac Conkey
Frasco 500 g
K25-611011
Agar M-ENDO LES
Frasco 500 g
K25-610024
Agar MRS
Frasco 500 g
K25-620627
Agar Mueller Hinton II
Frasco 100 g
K25-610627
Agar Mueller Hinton II
Frasco 500 g
K25-620033
Agar Mueller Hinton
Frasco 100 g
K25-610033
Agar Mueller Hinton
Frasco 500 g
K25-620036
Agar Nutriente
Frasco 100 g
K25-610036
Agar Nutriente
Frasco 500 g
K25-610002
Agar Peptona Dextrose
Frasco 500 g
K25-610129
Agar R2A
Frasco 500 g
K25-610203
Agar Sabouraud Cloranfenicol
Frasco 500 g
K25-620103
Agar Sabouraud Dextrose
Frasco 100 g
K25-610103
Agar Sabouraud Dextrose
Frasco 500 g
Imagens meramente ilustrativas. Produtos não passíveis de regulamentação,
conforme estabelece a nota técnica n° 001/2012/GEVIT/GGTPS/ANVISA.
144
Descrição
Apresentação
K25-620029
Agar Sal Manitol Base
Frasco 100 g
K25-610029
Agar Sal Manitol
Frasco 500 g
K25-610042
Agar Salmonella Shigella (SS)
Frasco 500 g
K25-610005
Agar Sangue Base
Frasco 500 g
K25-610078
Agar Soro de Laranja
Frasco 500 g
K25-611401
Agar Sulfito Ferro
Frasco 500 g
K25-620055
Agar Tríplice Açúcar Ferro (TSI)
Frasco 100 g
K25-610055
Agar Tríplice Açúcar Ferro (TSI)
Frasco 500 g
K25-620052
Agar Triptona de Soja (TSA)
Frasco 100 g
K25-610052
Agar Triptona de Soja (tsa)
Frasco 500 g
K25-610107
Agar Ureia Base
Frasco 500 g
K25-610009
Agar Verde Brilhante
Frasco 500 g
K25-610060
Agar XLD
Frasco 500 g
K25-611014
Água Peptona Tamponada
Frasco 500 g
K25-610038
Água Peptona
Frasco 500 g
K25-610206
Água Triptona
Frasco 500 g
K25-610003
Caldo Azida Dextrose
Frasco 500 g
K25-610208
Caldo Base Letheen
Frasco 500 g
K25-610106
Caldo Batata Dextrose
Frasco 500 g
K25-610010
Caldo Bile Verde Brilhante 2%
Frasco 500 g
K25-610072
Caldo Czapek Dox
Frasco 500 g
K25-610091
Caldo Demi Fraser Base
Frasco 500 g
K25-610063
Caldo EC
Frasco 500 g
K25-620008
Caldo Infusão Cérebro e Coração
Frasco 100 g
K25-610008
Caldo Infusão Cérebro e Coração
Frasco 500 g
K25-611202
Caldo Lactose
Frasco 500 g
meios de cultura
Modelo
Imagens meramente ilustrativas. Produtos não passíveis de regulamentação,
conforme estabelece a nota técnica n° 001/2012/GEVIT/GGTPS/ANVISA.
145
Modelo
meios de cultura
Descrição
Apresentação
K25-610085
Caldo Lauril Triptose
Frasco 500 g
K25-610171
Caldo Mac Conkey
Frasco 500 g
K25-610025
Caldo MRS
Frasco 500 g
K25-610032
Caldo MR-VP
Frasco 500 g
K25-610034
Caldo Mueller Hinton
Frasco 500 g
K25-610037
Caldo Nutriente
Frasco 500 g
K25-610175
Caldo Rappaport vassiliadis
Frasco 500 g
K25-610104
Caldo Sabouraud Dextrose
Frasco 500 g
K25-610150
Caldo Selenito Cistina
Frasco 500 g
K25-610163
Caldo Shigella
Frasco 500 g
K25-610051
Caldo Todd Hewitt
Frasco 500 g
K25-620053
Caldo Triptona Soja (TSB)
Frasco 100 g
K25-610053
Caldo Triptona Soja (TSB)
Frasco 500 g
K25-610497
Extrato de Carne
Frasco 500 g
K25-611005
Extrato de Levedura
Frasco 500 g
K25-611006
Extrato de Malte
Frasco 500 g
K25-611402
Meio de Transporte Cary-Blair
Frasco 500 g
K25-610022
Meio GC
Frasco 500 g
K25-610084
Meio LB (Luria Bertani)
Frasco 500 g
K25-610181
Meio SIM
Frasco 500 g
K25-610050
Meio Tioglicolato
Frasco 500 g
K25-610185
Meio Tríptico Cistina (CTA)
Frasco 500 g
K25-611701
Peptona Bacteriológica
Frasco 500 g
K25-611502
Peptona de Caseína
Frasco 500 g
K25-612501
Peptona de Soja
Frasco 500 g
K25-611004
Triptona
Frasco 500 g
Imagens meramente ilustrativas. Produtos não passíveis de regulamentação,
conforme estabelece a nota técnica n° 001/2012/GEVIT/GGTPS/ANVISA.
146
Modelo
Descrição
Apresentação
80272
Cloreto Férrico 10%*
2 x 25 mL
80219
Emulsão Gema de Ovo
4 frascos/caixa
80122
Emulsão Telurito Gema de Ovo
4 x 50 mL
81009
Solução de Iodo*
5 x 10 mL
81029
Suplemento Ácido Rosólico*
10 frascos/caixa
81016
Suplemento Bacillus cereus
10 frascos/caixa
81031
Suplemento Canamicina/Polimixina-b*
10 frascos/caixa
81017
Suplemento Cloranfenicol
10 frascos/caixa
81011
Suplemento Clostridium perfringens (TSC)
10 frascos/caixa
81048
Suplemento CNA*
10 frascos/caixa
81040
Suplemento Gardnerella*
10 frascos/caixa
81033
Suplemento Gentamicina*
10 frascos/caixa
80021
Suplemento Glicerol*
4 x 50 mL
81014
Suplemento Haemophilus*
10 frascos/caixa
81012
Suplemento L.C.A.T*
10 frascos/caixa
80008
Suplemento Letheen*
4 x 50 mL
81057
Suplemento RPF*
8 frascos/caixa
80046
Suplemento Triton x 100*
5 x 5 mL
80300
Suplemento TTC 1%*
5 x 10 mL
meios de cultura
Suplementos
Imagens meramente ilustrativas. Produtos não passíveis de regulamentação,
conforme estabelece a nota técnica n° 001/2012/GEVIT/GGTPS/ANVISA.
147
Modelo
Descrição
Apresentação
80031
Suplemento Tween 80*
2 x 50 mL
80292
Suplemento Ureia 40%
10 x 5 mL
81041
Suplemento V.C.A.T*
10 frascos/caixa
81022
Suplemento V.C.N*
10 frascos/caixa
81024
Suplemento V.C.N.T*
10 frascos/caixa
81023
Suplemento Vitalex*
10 frascos/caixa
80010
Suplemento XLT 4 (Tergitol 4)*
2 x 50 mL
meios de cultura
Nota: todos os suplementos serão comercializados com a marca Liofilchem.
*Produtos vendidos sob consulta.
Imagens meramente ilustrativas. Produtos não passíveis de regulamentação,
conforme estabelece a nota técnica n° 001/2012/GEVIT/GGTPS/ANVISA.
148